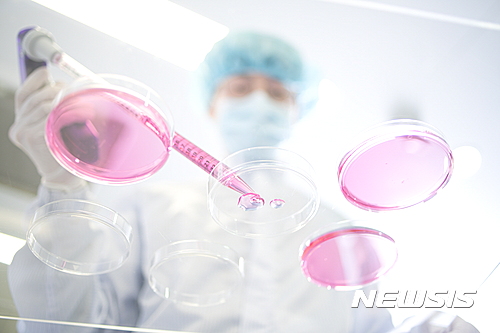

치매·알츠하이머병 환자 2050년 1억3500만명 전망
국내도 2050년 217만명 예상…치매노인 비중 2050년 5.6%
동아ST·일동제약·메디포스트·동국제약·대화제약·차이바오텍 등 도전
【서울=뉴시스】류난영 기자 = 인구 고령화로 인해 대표적인 노인성질환인 치매 관련 의료비가 크게 늘어날 것으로 예상되면서 관련 치료제 개발이 활발하게 이뤄지고 있다.
하지만 아직까지 전세계에서 개발된 효과적인 치매치료제는 없다. 치매치료제는 다른 치료제에 비해 실패 확률이 높고 개발이 까다롭다. 2003년 머츠의 '나멘다'가 미국 FDA로부터 승인 받은 후 지금까지 15년이 지났지만 새로 허가된 사례가 없을 정도다.
25일 제약업계에 따르면 미국 식품의약국(FDA)으로부터 허가받아 현재 시판 중인 알츠하이머병 치료제는 에자이의 '아리셉트', 노바티스의 '엑셀론', 머츠의 '나멘다', 존슨앤존슨의 '라자딘'등 4개에 불과하다. 가장 먼저 개발된 워너 램버트의 '코그넥스'는 1994년 미 FDA의 허가를 받았지만 현재는 사용되지 않고 있다.
하지만 이들 약들은 증세를 완화하거나 치매의 진행속도를 다소 늦출 뿐 치매의 근본원인인 뇌세포 손상을 최소화 시키는 약이라 치매 치료제로서는 역부족이다.
국제알츠하이머병협회(ADI)에 따르면 전세계 치매·알츠하이머병 환자수는 2013년 4400만명에서 2050년 1억3500만명으로 3배 이상 급증할 전망이다. 이로인해 글로벌 치매치료제 시장 규모도 지난 2015년 기준 3조5000억원에서 오는 2024년 13조5000억원으로 성장이 예상된다.
우리나라 역시 고령화로 인해 치매·알츠하이머병 환자도 급격하게 증가할 전망이다. 국회예산정책처에 따르면 65세 이상 노인인구의 치매 환자는 2014년 61만명으로 이미 60만명을 돌파했다. 2020년 84만명, 2050년 217만명으로 급증할 것으로 전망된다. 전체 인구 대비 65세 이상 치매 노인의 비중도 2012년 1.1%에서 2050년 5.6%로 5배 넘게 증가할 것으로 예상된다.
치료제 개발이 지연되면서 알츠하이머병으로 인한 사망자 수도 늘고 있다. 미국의 경우 2013년 뇌졸중과 심장질환, 전립선암으로 인한 사망건수가 2000년에 비해 각각 23%, 14%, 11% 감소했지만 같은 기간 알츠하이머병으로 인한 사망건수는 71% 증가했다. 이는 알츠하이머병이 다른 질환과 비교해 임상연구나 신약개발이 미흡하다는 사실을 보여주는 것이다.
닐슨코리아에 따르면 한국 내 치매 관련 경제·사회적 비용은 2013년 11조7000억원(GDP의 1.0%)에서 2050년 43조2000억원(1.5%)으로 증가할 것으로 예상된다. 또 국제알츠하이머협회는 2025년에 알츠하이머병의 발병을 5년 지연시키는 신약이 허가될 경우 2050년에 치매 환자 수가 40% 감소하고 의료비용도 3670억달러 절감할 수 있을 것으로 추정된다고 전망했다.
그럼에도 불구하고 알츠하이머병 치료제 개발이 더딘 것은 임상시험에서의 실패율이 높기 때문이다. 그동안 수 많은 글로벌 빅파마들은 알츠하이머병 치료제 개발에 뛰어들었으나 대부분 마지막 단계인 임상 3상에서 실패했다.
치매를 유발하는 베타아밀로이드의 생성을 억제하는 신약에 대한 임상시험도 2001년에 이르러서야 시작됐고 현재까지 이와 관련된 임상시험은 대부분 실패했고, 개발된 신약도 아직 없다.
치매치료제 중 가장 마지막에 개발된 '나멘다'가 미국 FDA로부터 승인(2003년) 받은 후 지금까지 10여년이 지났지만 알츠하이머병 치료제가 새로 허가된 사례도 없다.
미국 클리블랜드 클리닉 뇌건강센터의 제프리 커밍스 박사에 따르면 알츠하이머병의 임상 실패율은 99.6%에 달한다. 커밍스 박사가 2002~2012년 사이에 개발된 치매치료 신약 413개의 임상시험 자료를 조사한 결과 FDA의 품목허가를 받은 경우는 단 1건에 불과했다.
미국 제약협회에 따르면 1998년부터 2014년까지 실패한 알츠하이머병 파이프라인 수는 123건인 반면 신약 허가 수는 4건에 불과하다. 전체 신약 개발 임상 2상, 3상 실패율(2006~2015년)은 각각 69%, 42%다. 알츠하이머병 신약 개발이 얼마나 어려운지 알 수 있는 대목이다.
국내 제약사들은 빅파파들이 실패한 영역인 천연물 등을 이용한 치매 치료제 개발을 시도하고 있다.
치매치료제 개발에 가장 적극적인 동아ST는 근본적 치매 치료제 개발을 위해 국내 제약사 중에는 최초로 2013년 민간 주도의 치매 전문 연구센터인 '동아치매센터'를 설립했다.
하지만 아직까지 전세계에서 개발된 효과적인 치매치료제는 없다. 치매치료제는 다른 치료제에 비해 실패 확률이 높고 개발이 까다롭다. 2003년 머츠의 '나멘다'가 미국 FDA로부터 승인 받은 후 지금까지 15년이 지났지만 새로 허가된 사례가 없을 정도다.
25일 제약업계에 따르면 미국 식품의약국(FDA)으로부터 허가받아 현재 시판 중인 알츠하이머병 치료제는 에자이의 '아리셉트', 노바티스의 '엑셀론', 머츠의 '나멘다', 존슨앤존슨의 '라자딘'등 4개에 불과하다. 가장 먼저 개발된 워너 램버트의 '코그넥스'는 1994년 미 FDA의 허가를 받았지만 현재는 사용되지 않고 있다.
하지만 이들 약들은 증세를 완화하거나 치매의 진행속도를 다소 늦출 뿐 치매의 근본원인인 뇌세포 손상을 최소화 시키는 약이라 치매 치료제로서는 역부족이다.
국제알츠하이머병협회(ADI)에 따르면 전세계 치매·알츠하이머병 환자수는 2013년 4400만명에서 2050년 1억3500만명으로 3배 이상 급증할 전망이다. 이로인해 글로벌 치매치료제 시장 규모도 지난 2015년 기준 3조5000억원에서 오는 2024년 13조5000억원으로 성장이 예상된다.
우리나라 역시 고령화로 인해 치매·알츠하이머병 환자도 급격하게 증가할 전망이다. 국회예산정책처에 따르면 65세 이상 노인인구의 치매 환자는 2014년 61만명으로 이미 60만명을 돌파했다. 2020년 84만명, 2050년 217만명으로 급증할 것으로 전망된다. 전체 인구 대비 65세 이상 치매 노인의 비중도 2012년 1.1%에서 2050년 5.6%로 5배 넘게 증가할 것으로 예상된다.
치료제 개발이 지연되면서 알츠하이머병으로 인한 사망자 수도 늘고 있다. 미국의 경우 2013년 뇌졸중과 심장질환, 전립선암으로 인한 사망건수가 2000년에 비해 각각 23%, 14%, 11% 감소했지만 같은 기간 알츠하이머병으로 인한 사망건수는 71% 증가했다. 이는 알츠하이머병이 다른 질환과 비교해 임상연구나 신약개발이 미흡하다는 사실을 보여주는 것이다.
닐슨코리아에 따르면 한국 내 치매 관련 경제·사회적 비용은 2013년 11조7000억원(GDP의 1.0%)에서 2050년 43조2000억원(1.5%)으로 증가할 것으로 예상된다. 또 국제알츠하이머협회는 2025년에 알츠하이머병의 발병을 5년 지연시키는 신약이 허가될 경우 2050년에 치매 환자 수가 40% 감소하고 의료비용도 3670억달러 절감할 수 있을 것으로 추정된다고 전망했다.
그럼에도 불구하고 알츠하이머병 치료제 개발이 더딘 것은 임상시험에서의 실패율이 높기 때문이다. 그동안 수 많은 글로벌 빅파마들은 알츠하이머병 치료제 개발에 뛰어들었으나 대부분 마지막 단계인 임상 3상에서 실패했다.
치매를 유발하는 베타아밀로이드의 생성을 억제하는 신약에 대한 임상시험도 2001년에 이르러서야 시작됐고 현재까지 이와 관련된 임상시험은 대부분 실패했고, 개발된 신약도 아직 없다.
치매치료제 중 가장 마지막에 개발된 '나멘다'가 미국 FDA로부터 승인(2003년) 받은 후 지금까지 10여년이 지났지만 알츠하이머병 치료제가 새로 허가된 사례도 없다.
미국 클리블랜드 클리닉 뇌건강센터의 제프리 커밍스 박사에 따르면 알츠하이머병의 임상 실패율은 99.6%에 달한다. 커밍스 박사가 2002~2012년 사이에 개발된 치매치료 신약 413개의 임상시험 자료를 조사한 결과 FDA의 품목허가를 받은 경우는 단 1건에 불과했다.
미국 제약협회에 따르면 1998년부터 2014년까지 실패한 알츠하이머병 파이프라인 수는 123건인 반면 신약 허가 수는 4건에 불과하다. 전체 신약 개발 임상 2상, 3상 실패율(2006~2015년)은 각각 69%, 42%다. 알츠하이머병 신약 개발이 얼마나 어려운지 알 수 있는 대목이다.
국내 제약사들은 빅파파들이 실패한 영역인 천연물 등을 이용한 치매 치료제 개발을 시도하고 있다.
치매치료제 개발에 가장 적극적인 동아ST는 근본적 치매 치료제 개발을 위해 국내 제약사 중에는 최초로 2013년 민간 주도의 치매 전문 연구센터인 '동아치매센터'를 설립했다.

동아치매센터에서는 동아에스티, 삼성서울병원, 차의과대학, 한국파스퇴르연구소와 함께 치매환자 유래 역분화 줄기세포를 이용한 치매질병모델을 개발해 치매의 진단 및 평가에 활용할 수 있는 플랫폼기술을 구축하는 연구를 진행하고 있다. 이를 활용해 향후 새로운 치매 타깃을 발굴할 수 있을 것으로 기대하고 있다.
동아ST는 천연물 소재를 기반 치매치료제 'DA-9803'의 전임상을 마치고 미국 제약사 '뉴로보 파마슈티컬스'에 500만 달러와 지분 24%를 수령하는 조건으로 기술수출했다. 이에 따라 'DA-9803'에 대한 개발은 뉴로보사가 전적으로 담당한다.
일동제약도 천연물 기반 치매치료제 후보물질 'ID1201'의 임상 2상을 진행중이다. 'ID1201'은 멀구슬나무의 열매인 천련자에서 추출한 천연물로 치매의 주요 발병 원인을 억제하고 신경세포를 보호하는 작용을 보여 새로운 치매치료제로서 가능성을 높이고 있다. 'ID1201'은 동물 시험에서 치매의 다양한 원인들을 차단해 인지기능을 개선하는 것으로 나타났다.
메디포스트는 동종 제대혈유래 중간엽줄기세포를 주성분으로 한 '뉴로스템'을 개발중이다. 지난 2월 미국 식품의약국(FDA)으로부터 경도 및 중등도 알츠하이머병 환자를 대상으로 '뉴로스템'의 임상 1∙2a상 시험계획을 승인받고, 현재 임상을 준비중이다. 국내에서도 삼성서울병원에서 임상 1·2a상을 진행중이다.
메디포스트는 2012년부터 5년여에 걸쳐 보건복지부의 줄기세포재생의료 실용화 컨소시엄 사업 과제의 지원을 받아 뉴로스템의 국내 및 해외 개발을 진행해 왔다.
동국제약은 1회 투여로 1개월간 약효가 지속되는 '도네페질 데포' 개발을 위해 2015년 말 식품의약품안전처로부터 임상 1상을 승인받고 현재 개발중이다.
대화제약도 도네페질로 치료를 받고 있는 경증 내지 중등증의 알츠하이머성 치매 환자를 대상으로 한 'DHP1401'의 임상 2b상을 진행중이다.
차바이오텍은 태반줄기세포 유래 알츠하이머병 치료제 'CB-AC-02'의 임상 1·2a상을 진행중이다. CB-AC-02는 태반 조직에서 추출한 줄기세포를 이용해 대량배양 기술과 세포동결 기술을 통해 별도의 배양기간이 필요한 주문 생산 방식이 아닌 기성품 형태로 공급하는 동결 세포치료제다. 정맥주사 방식으로 투여돼 기존 뇌수술을 필요로 하던 투여 방식에 비해 위험 부담을 덜어줄 것으로 기대된다.
이밖에도 대웅제약, 제일약품 등도 치매치료제 개발을 위한 초기 임상을 진행 중이다. 이들 치료제 개발은 현재 임상 1상~2상 단계기 대부분이라 상용화까지는 시간이 걸릴 것으로 예상된다.
전문가들은 치매치료 신약 개발이 더딘 것과 관련 알츠하이머병에 대한 정보가 부족한 데다 성공률이 지나치게 적어 막대한 비용이 소요되기 때문이라고 지적하고 있다.
KDB산업은행 기술평가부 엄기현 선임연구원은 "최근 15년 동안 실패한 임상시험은 120여건에 달하고 대부분 후기 임상단계에서 중단돼 막대한 손실이 발생했다"며 "알츠하이머병 신약개발이 후기 임상단계에서 주로 실패하는 이유는 초기 임상단계에서 효능·안전성 등이 충분히 검증되지 않은 상태에서 다음 단계로 진행시키기 때문"이라고 분석했다.
업계 관계자는 "치매치료제 개발은 항암제 등에 비해 더 많은 시간과 노력이 투자되지만 높은 실패율이 제약사에 위험부담으로 작용해 글로벌 제약사들 조차도 관련 R&D 지출을 줄이고 있는 실정"이라며 "하지만 인구고령화로 인해 치매로부터 고통 받는 환자들과 가족들을 위한 근본적인 치매치료제가 요구되고 있어 많은 제약사들이 치매치료제 개발에 뛰어 들고 있다"고 말했다.
[email protected]
동아ST는 천연물 소재를 기반 치매치료제 'DA-9803'의 전임상을 마치고 미국 제약사 '뉴로보 파마슈티컬스'에 500만 달러와 지분 24%를 수령하는 조건으로 기술수출했다. 이에 따라 'DA-9803'에 대한 개발은 뉴로보사가 전적으로 담당한다.
일동제약도 천연물 기반 치매치료제 후보물질 'ID1201'의 임상 2상을 진행중이다. 'ID1201'은 멀구슬나무의 열매인 천련자에서 추출한 천연물로 치매의 주요 발병 원인을 억제하고 신경세포를 보호하는 작용을 보여 새로운 치매치료제로서 가능성을 높이고 있다. 'ID1201'은 동물 시험에서 치매의 다양한 원인들을 차단해 인지기능을 개선하는 것으로 나타났다.
메디포스트는 동종 제대혈유래 중간엽줄기세포를 주성분으로 한 '뉴로스템'을 개발중이다. 지난 2월 미국 식품의약국(FDA)으로부터 경도 및 중등도 알츠하이머병 환자를 대상으로 '뉴로스템'의 임상 1∙2a상 시험계획을 승인받고, 현재 임상을 준비중이다. 국내에서도 삼성서울병원에서 임상 1·2a상을 진행중이다.
메디포스트는 2012년부터 5년여에 걸쳐 보건복지부의 줄기세포재생의료 실용화 컨소시엄 사업 과제의 지원을 받아 뉴로스템의 국내 및 해외 개발을 진행해 왔다.
동국제약은 1회 투여로 1개월간 약효가 지속되는 '도네페질 데포' 개발을 위해 2015년 말 식품의약품안전처로부터 임상 1상을 승인받고 현재 개발중이다.
대화제약도 도네페질로 치료를 받고 있는 경증 내지 중등증의 알츠하이머성 치매 환자를 대상으로 한 'DHP1401'의 임상 2b상을 진행중이다.
차바이오텍은 태반줄기세포 유래 알츠하이머병 치료제 'CB-AC-02'의 임상 1·2a상을 진행중이다. CB-AC-02는 태반 조직에서 추출한 줄기세포를 이용해 대량배양 기술과 세포동결 기술을 통해 별도의 배양기간이 필요한 주문 생산 방식이 아닌 기성품 형태로 공급하는 동결 세포치료제다. 정맥주사 방식으로 투여돼 기존 뇌수술을 필요로 하던 투여 방식에 비해 위험 부담을 덜어줄 것으로 기대된다.
이밖에도 대웅제약, 제일약품 등도 치매치료제 개발을 위한 초기 임상을 진행 중이다. 이들 치료제 개발은 현재 임상 1상~2상 단계기 대부분이라 상용화까지는 시간이 걸릴 것으로 예상된다.
전문가들은 치매치료 신약 개발이 더딘 것과 관련 알츠하이머병에 대한 정보가 부족한 데다 성공률이 지나치게 적어 막대한 비용이 소요되기 때문이라고 지적하고 있다.
KDB산업은행 기술평가부 엄기현 선임연구원은 "최근 15년 동안 실패한 임상시험은 120여건에 달하고 대부분 후기 임상단계에서 중단돼 막대한 손실이 발생했다"며 "알츠하이머병 신약개발이 후기 임상단계에서 주로 실패하는 이유는 초기 임상단계에서 효능·안전성 등이 충분히 검증되지 않은 상태에서 다음 단계로 진행시키기 때문"이라고 분석했다.
업계 관계자는 "치매치료제 개발은 항암제 등에 비해 더 많은 시간과 노력이 투자되지만 높은 실패율이 제약사에 위험부담으로 작용해 글로벌 제약사들 조차도 관련 R&D 지출을 줄이고 있는 실정"이라며 "하지만 인구고령화로 인해 치매로부터 고통 받는 환자들과 가족들을 위한 근본적인 치매치료제가 요구되고 있어 많은 제약사들이 치매치료제 개발에 뛰어 들고 있다"고 말했다.
[email protected]





